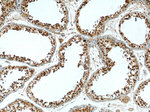
PSMD4 Antibody in Immunohistochemistry (Paraffin) (IHC (P))

Search
Proteintech
PSMD4 Polyclonal Antibody
{{$productOrderCtrl.translations['antibody.pdp.commerceCard.promotion.promotions']}}
{{$productOrderCtrl.translations['antibody.pdp.commerceCard.promotion.viewpromo']}}
{{$productOrderCtrl.translations['antibody.pdp.commerceCard.promotion.promocode']}}: {{promo.promoCode}} {{promo.promoTitle}} {{promo.promoDescription}}. {{$productOrderCtrl.translations['antibody.pdp.commerceCard.promotion.learnmore']}}
产品信息
14899-1-AP
种属反应
已发表种属
宿主/亚型
分类
类型
抗原
偶联物
形式
浓度
规格
纯化类型
保存液
内含物
保存条件
运输条件
产品详细信息
This antibody is specific to PSMD4.
Immunogen sequence: MVLESTMVC VDNSEYMRNG DFLPTRLQAQ QDAVNIVCHS KTRSNPENNV GLITLANDCE VLTTLTPDTG RILSKLHTVQ PKGKITFCTG IRVAHLALKH RQGKNHKMRI IAFVGSPVED NEKDLVKLAK RLKKEKVNVD IINFGEEEVN TEKLTAFVNT LNGKDGTGSH LVTVPPGPSL ADALISSPIL AGEGGAMLGL GASDFEFGVD PSADPELALA LRVSMEEQRQ RQEEEARRAA AASAAEAGIA TTGTEDSDDA LLKMTISQQE FGRTGLPDLS SMTEEEQIAY AMQMSLQGAE FGQAESADID ASSAMDTSEP AKEEDDYDVM QDPEFLQSVL ENLPGVDPNN EAIRNAMGSL ASQATKDGKK DKKEEDKK (1-377 aa encoded by BC002365)
靶标信息
This gene encodes a subunit of the elongation factor-1 complex, which is responsible for the enzymatic delivery of aminoacyl tRNAs to the ribosome. This subunit functions as guanine nucleotide exchange factor. It is reported that this subunit interacts with HIV-1 Tat, and thus it represses the translation of host-cell, but not HIV-1, mRNAs. Several alternatively spliced transcript variants encoding multiple isoforms have been found for this gene.
仅用于科研。不用于诊断过程。未经明确授权不得转售。
生物信息学
蛋白别名: 26S proteasome non-ATPase regulatory subunit 4; 26S proteasome regulatory subunit RPN10; 26S proteasome regulatory subunit S5A; AF; angiocidin; anti secretory factor 1; antisecretory factor; Antisecretory factor 1; Multiubiquitin chain-binding protein; multiubiquitin-chain-binding protein; proteasome (prosome, macropain) 26S subunit, non-ATPase, 4; proteasome 26S subunit, non-ATPase 4; RP11-126K1.1; RPN10 homolog; S5a/antisecretory factor protein
基因别名: AF; AF-1; Af1; angiocidin; ASF; MCB1; PSMD4; pUB-R5; Rpn10; S5A
UniProt ID: (Human) P55036, (Mouse) O35226
Entrez Gene ID: (Human) 5710, (Mouse) 19185, (Rat) 83499